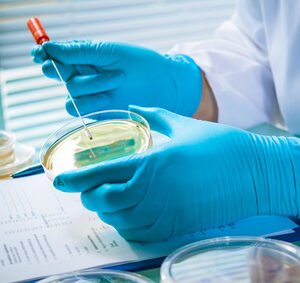
Buenas Prácticas de Laboratorio

¡Aprovecha nuestros precios de descuento por el Cyber Korval!
Cursos Certificados
Profesores Expertos
Soporte las 24h
100% Online
Conoce nuestros cursos
Conócenos
Alumnos inscritos
+
0
Certificados ISO
+
0
De clases online
+
0
h
Cursos Publicados
+
0